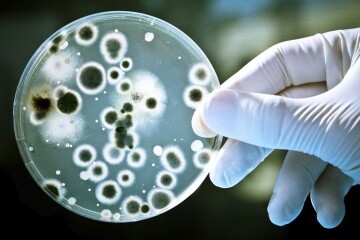

Antibiyotik direnci, bir antibiyotik bakterileri öldürme veya kontrol etme yeteneğini kaybettiğinde ortaya çıkar. Bu durumda, bakteriler dirençlidir ve iyileştirici dozda antibiyotik varlığında bile çoğalmaya devam eder.
Bir antibiyotik kullanıldığında vücuttaki bakteriler antibiyotiğe dirençli hale gelir, hayatta kalır ve kalan bakteriler ölür. Ortamda sadece dirençli bakteriler kalır.
Bazı direnç mekanizmaları insan etkisi olmadan gerçekleşir. Çünkü bakteriler de antibiyotik üretebilir ve bu antibiyotiği diğer bakterilere karşı kullanabilir. Sonuç olarak, yalnızca üretken antibiyotiğe dirençli bakteriler kalır. Buna rağmen günümüzde ortaya çıkan büyük miktarda antibiyotiğe dirençli bakteri, antibiyotiklerin aşırı kullanımı sonucu ortaya çıkmıştır. Bazı ülkelerde, antibiyotikler doktor reçetesi olmadan çevrimiçi olarak satın alınabilir. Ayrıca, bazen hastalar soğuk algınlığı gibi viral hastalıkları tedavi etmek için gereksiz yere antibiyotik alırlar. Antibiyotiklerin bu şekilde kullanılması dirençli bakteri sayısını artırır. Bu görüntü aynı zamanda dünya çapında sağlık için büyük bir tehdittir. Çünkü antibiyotiğe dirençli bakteri sayısının artmasıyla birlikte elimizdeki ilaçlar işe yaramaz hale gelecek ve hastalıkları tedavi etmek için yeni antibiyotiklerin geliştirilmesine acil ihtiyaç duyulacaktır.
Bazı bakteriler farklı antibiyotiklere doğal olarak dirençlidir. Ayrıca bakteriler iki şekilde de direnç kazanabilirler. bu yöntemler; Direncin genetik bir mutasyon yoluyla kazanılması veya diğer bakterilerden direnç kazanılmasıdır.
mutasyonlar. Bakterilerin genetik materyalinde kendiliğinden meydana gelen nadir değişikliklerdir. Milyonda bir hücrede meydana geldiği düşünülmektedir. Farklı genetik mutasyonlar, farklı direnç türleri üretir. Bazı mutasyonlar, bakterilerin antibiyotiği nötralize eden enzimler üretmesine neden olur. Bazı mutasyonlar, antibiyotiğin saldırdığı hücre bileşenini de ortadan kaldırır. Diğer durumlarda ise antibiyotiğin hücreye girdiği kanallar kapanır ya da antibiyotik girdiğinde yeni bir kanal mekanizması ile görev yapamadan antibiyotik elimine edilir.
Bakteriler, diğer bakterilerden çeşitli yollarla antibiyotik direnç genleri alabilir. Bakteriler genetik materyallerini konjugasyon adı verilen bir mekanizma ile birbirlerine aktarabilirler. Antibiyotik direnç genleri de bir bakteriden diğerine bu şekilde aktarılabilir. Virüsler, direnç genlerinin bakteriler arasında yayılabileceği başka bir mekanizmadır. Bakterilerdeki direnç genleri bir virüs içinde kapsüllenir. Virüsler, direnç genlerini enfekte ettikleri herhangi bir bakteriye aktarabilirler. Ayrıca bakteriler, çevrelerinde bulunan çıplak DNA moleküllerini hücreye aktarma yeteneğine de sahiptir.
Herhangi bir bakteri, diğer bakterilerle mutasyon veya gen değişimi yoluyla antibiyotik direnç genleri alabilir ve bir veya daha fazla antibiyotiğe direnç kazanabilir. Çünkü bakteriler zamanla birden fazla direnç özelliği biriktirebilir.
Antibiyotik direnci nasıl yayılır?
Bakteriler çoğaldıklarında antibiyotiğe dirençli geni yeni nesillere aktarırlar, dolayısıyla dirençli bakteri sayısı artmaya devam eder. Ek olarak, farklı bakteri türleri arasında direnç genlerinin değişimi gerçekleşir. Ekolojik açıdan bakıldığında, antibiyotik direnç genleri bakteriler aracılığıyla bir yerden başka bir yere yayılmaktadır. bakteri; Çevrede hava, su ve rüzgar yoluyla yayılabilir. İnsanlar ayrıca dirençli bakterileri öksürerek veya yıkanmamış ellere dokunarak bir kişiden diğerine bulaştırabilir.
Bakteriler antibiyotik direncini kaybeder mi? Bakteriler antibiyotik direncini kaybedebilir ama bu uzun bir süreçtir. Bunun için dirençli hale gelen bir antibiyotiğin atılması gerekir. Bu nedenle dirençli bakterilerin diğer bakterilere göre hiçbir avantajı yoktur. Diğer bakteri türleri çoğalmaya başladıkça, dirençli bakteri oranı giderek azalır.
Antibiyotik direnciyle mücadele için alınan önlemler
İyi hijyen uygulamaları, dirençli bakteri ve hastalıkların yayılmasını önlemek için en iyi önlemdir. Sabun ve su ile sık sık el yıkamak hastalıkların yayılmasını engeller. Yemek hazırlığı sırasında eti iyice pişirmek ve gıda türevli antibakteriyel sabunlar hazırlarken hijyenik olarak kullanmak hastanelerde yararlı olabilir, ancak bu sabunların antibiyotik direncini artırabileceğine dair endişeler vardır. Ayrıca, yararlılıkları henüz kanıtlanmamıştır.
Bu konuda bireylerin alabilecekleri bir diğer önlem de antibiyotiğin etkisini sürdürebilmesi için aşırı kullanımdan kaçınmaktır. Bu nedenle sadece doktorunuzun tavsiye ettiği uygun dozlarda kullanılmalıdır.
Dünya Sağlık Örgütü (WHO), dünya çapında artan sayıda dirençli bakteriden endişe duymaktadır. Bu konuda küresel koordinasyonu sağlamak için Dünya Sağlık Örgütü, hükümetleri bu konuda harekete geçmeye teşvik eden bir belge yayınladı.
Gelişmekte olan ülkelerin antibiyotiklere erişimi kısıtlaması gerekiyor. Ayrıca temiz su kaynaklarının sağlanması ve tarım ve hayvancılıkta antibiyotik kullanımının azaltılmasına ihtiyaç vardır. Uzmanlar, küresel bir antibiyotik direnci takip sisteminin gerekli olduğu konusunda hemfikir. Böyle bir sistem geliştirilebilirse mevcut önlemlerin yeterli olup olmadığını görebiliriz.
Antibiyotik direnciyle mücadele etmek için bilim adamları, bakterilerde direnç sağlayan enzimin antibiyotiği inaktive edememesi için mevcut antibiyotikleri değiştirirler. Bu stratejiye alternatif olarak bakteri direncine neden olan enzim, bir katkı maddesi molekülü tarafından baskılanır. Hem dirençli hem de salgın bakteriler (belirli bir bölgede yaygın olan), yeni bir antibiyotik geliştirilerek kontrol edilebilir. Yeni bir antibiyotik üretmek uzun ve pahalı bir süreçtir. Yaklaşık 10 yıl sürer ve 300 milyon dolara mal olur. Ancak yeni geliştirilen antibiyotiklerin yanlış kullanımı iki yıl içinde dirençli bakterilerin ortaya çıkmasına neden olabilir. Bu nedenle bilim adamları sürekli olarak yeni antibiyotikler arıyorlar.
kaynak:
http://emerald.tufts.edu/med/apua/about_issue/about_antibioticres.shtml
http://emerald.tufts.edu/med/apua/about_issue/what_can_be_done.shtml
yazar: Ayka Olkay
Diğer gönderilerimize göz at
[wpcin-random-posts]